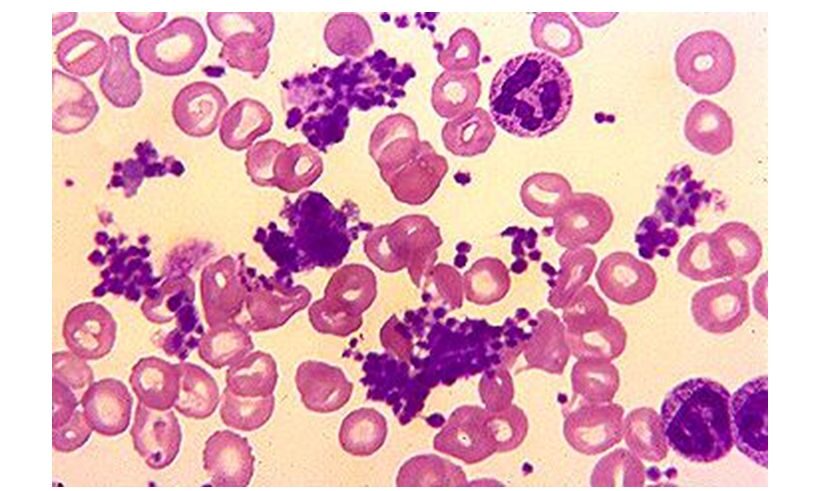
Essential Thrombocythemia Market

The global essential thrombocythemia market is on track for significant expansion, with projections indicating a valuation of USD 865.36 million by 2023 and a robust compound annual growth rate (CAGR) of 5.8% from 2023 to 2033. By 2033, the market is anticipated to reach an impressive USD 1,520.74 million.
Essential thrombocythemia, a rare blood disorder affecting 1 to 24 individuals per million worldwide, has seen a notable increase in prevalence. This rise is attributed in part to the growing adoption of medications such as aspirin among patients, a key driver fueling market growth. Furthermore, the market is poised to capitalize on emerging opportunities spurred by the rising incidence of essential thrombocythemia in pediatric populations.
Request A Sample Report: https://www.futuremarketinsights.com/reports/sample/rep-gb-12171
The market dynamics are indicative of a thriving landscape, with pharmaceutical companies and stakeholders gearing up to cater to the rising demand for essential thrombocythemia therapeutics. The continuous research and development activities in the field aim to enhance treatment options, further propelling the market forward.
Key Highlights:
- The essential thrombocythemia market is projected to grow to USD 865.36 million in 2023.
- Anticipated compound annual growth rate (CAGR) of 5.8% from 2023 to 2033.
- Estimated market valuation of USD 1,520.74 million by 2033.
- Increasing popularity of drugs such as aspirin among patients is a significant motivating factor.
- Growing incidence of essential thrombocythemia in children opens new opportunities for market participants.
As the market continues to evolve, pharmaceutical companies and research institutions are focusing on innovative therapies to address the diverse needs of patients suffering from essential thrombocythemia. The positive trajectory of the market showcases the potential for significant advancements in therapeutic options and underscores the importance of collaborative efforts within the healthcare industry.
The Market is driven By a Number of Factors, Including:
- Rising incidence of ET: ET is a rare blood disorder characterized by an abnormally high platelet count. The incidence of ET is estimated to be 1 to 24 per million people worldwide.
- Increasing awareness of ET: As awareness of ET increases, more people are being diagnosed with the condition. This is leading to a greater demand for ET treatments.
- Growing aging population: The aging population is more susceptible to ET. As the population ages, the market for ET treatments is expected to grow.
- Development of new treatments: There are a number of new treatments for ET in development. These new treatments are expected to improve the outcomes for patients with ET and drive market growth.
The ET market is dominated by a few large players, such as Novartis, Bristol-Myers Squibb, and Pfizer. These companies have a number of drugs on the market for ET, including hydroxyurea, interferon-alpha, and anagrelide. However, there is a growing number of smaller companies entering the market with new and innovative treatments.
The ET market is a relatively small market, but it is expected to grow at a steady pace over the next decade. The increasing incidence of ET, the growing aging population, and the development of new treatments are all factors that are expected to drive market growth.
Customization in Our Resourceful Report: https://www.futuremarketinsights.com/customization-available/rep-gb-12171
Here are some of the key trends that are expected to shape the ET market in the coming years:
- Precision medicine: Precision medicine is an approach to treating diseases that takes into account the individual’s genetic makeup and other biomarkers. This approach is expected to lead to the development of more effective treatments for ET.
- Gene therapy: Gene therapy is a type of treatment that involves replacing or correcting a faulty gene. Gene therapy is still in its early stages of development, but it has the potential to cure ET.
- Stem cell therapy: Stem cell therapy is a type of treatment that involves using stem cells to repair or replace damaged tissue. Stem cell therapy is also in its early stages of development, but it has the potential to cure ET.
The ET market is a promising market with a number of growth opportunities. The development of new and innovative treatments is expected to drive market growth in the coming years.
Some of the key market players in Essential thrombocythemia treatment market are:
- Merck & Co., Incyte Corp
- Bayer pharmaceuticals
- USV
- Teva Pharmaceutical Industries Ltd
- Sandoz (Novartis AG)
- AstraZeneca plc
- Pfizer Inc
- Bristol Myers Squibb Company
- Shire Plc
Essential thrombocythemia market segment:
The global market for Essential thrombocythemia is segmented based on the treatment drug type, end user, and region
By Treatment Drug Type:
- Aspirin
- Hydroxyurea
- Anagrelide
- Interferon
By End-user:
- Hospitals
- Research organizations
- Specialty clinics
Regional Analysis Includes:
- North America
- Latin America
- Europe
- Asia Pacific
- Middle East & Africa
A Full Report Overview: https://www.futuremarketinsights.com/checkout/12171
About Future Market Insights (FMI)
Future Market Insights, Inc. (ESOMAR certified, recipient of the Stevie Award, and a member of the Greater New York Chamber of Commerce) offers profound insights into the driving factors that are boosting demand in the market. FMI stands as the leading global provider of market intelligence, advisory services, consulting, and events for the Packaging, Food and Beverage, Consumer Technology, Healthcare, Industrial, and Chemicals markets. With a vast team of over 400 analysts worldwide, FMI provides global, regional, and local expertise on diverse domains and industry trends across more than 110 countries.
Contact Us:
Future Market Insights Inc.
Christiana Corporate, 200 Continental Drive,
Suite 401, Newark, Delaware – 19713, USA
T: +1-845-579-5705
For Sales Enquiries: sales@futuremarketinsights.com
Website: https://www.futuremarketinsights.com
LinkedIn| Twitter| Blogs | YouTube